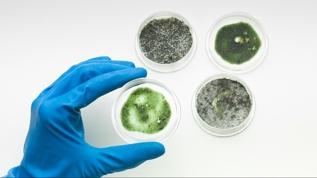
Dünyanın atık sularında süper mikropların sırları bulundu

Sağlık Bakanlığı'ndan 2 bin 764 işçi alımı: Başvurular başlıyor

Sağlık Bakanlığı 2.764 işçi alımı ilanı yayımlandı. İşçi alımı başvuru süreci İŞKUR üzerinden yürütülecek. Bakanlık temizlik, güvenlik, bakım-onarım gibi alanlarda görevlendirilmek üzere işçi alımı yapacak. Başvuru detayları ve şartlar Resmi Gazete'de yayımlandı.
Sağlık Bakanlığının 2 bin 764 sürekli işçi alım ilanı Resmi Gazete'de yayımlandı.
Bakanlığın taşra teşkilatında istihdam edilmek üzere 2 bin 764 sürekli işçi alımına yönelik ilanlara, "esube.iskur.gov.tr", "yhgm.saglik.gov.tr" ve "kamuilan.sbb.gov.tr" internet adreslerinden ulaşılabiliyor.
Başvurular, 13 Ekim'e kadar Türkiye İş Kurumu (İŞKUR) "esube.iskur.gov.tr" adresi üzerinden elektronik (çevrim içi) kullanıcı girişi yapılarak alınacak.
Alımlar, ihtiyaç duyulan hizmet türlerine göre il düzeyinde yapılacak. Başvurularda, kişilerin Adrese Dayalı Nüfus Kayıt Sistemi'ndeki adresleri dikkate alınacak.
Adaylar, ilan edilen kadrolardan yalnızca bir iş yeri ve mesleğe başvuru yapabilecek.
Sürekli işçi kadrolarının meslek ve kadro sayısına göre dağılımlarına bakıldığında, 1948 temizlik görevlisi, 572 silahsız güvenlik görevlisi, 244 hastane klinik destek elemanı alınacak.
- Popüler Haberler -

Mitokondri DNA'sı yaşlanmada iltihaplanmaya neden oluyor

Taze sebzeleriniz toprağın plastik kirliliğini içeriyor olabilir!

Bilim insanları açıkladı; Krom takviyeleri gerçekten işe yarıyor mu?

Uzmanlar uyarıyor: Diabetes insipidus sandığınızdan daha tehlikeli olabilir

Araştırma ortaya koydu; Kadınların beyni aylık döngüde değişiyor

Semaglutid ilaçları yemek düşüncelerini önemli ölçüde azaltıyor